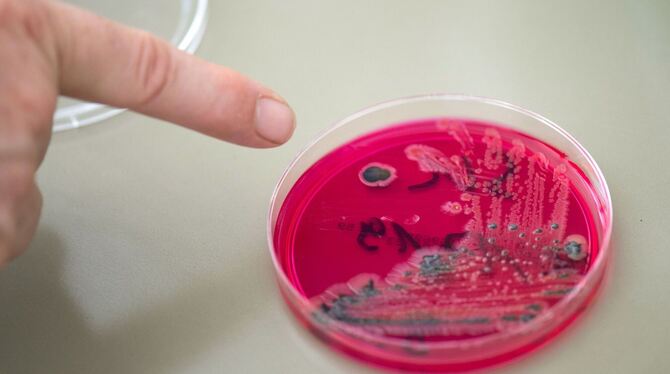

Ein Salmonellenausbruch in Verbindung mit Hühnerfleisch hat mittlerweile 16 Länder erfasst. Wie die EU-Gesundheitsbehörde ECDC mitteilte, wurden vom Januar bis 24. Oktober 335 bestätigte Fälle aus 15 europäischen Ländern sowie den USA gemeldet.
Hühnerfleisch, das unter anderem in Kebab verwendet worden sei, gelte als wahrscheinliche Quelle des Ausbruchs, der drei verschiedene Gruppen von Salmonella Enteritidis ST11 umfasse, schrieb die in Stockholm ansässige Behörde in einer gemeinsamen Einschätzung mit der Europäischen Lebensmittelbehörde Efsa. Man rechne damit, dass es weitere Fälle geben werde.
Bakterien, die denjenigen ähnelten, die den Ausbruch verursachten, seien in Proben von Hühnerfleisch und in Hühner-Kebab entdeckt worden, erklärten die beiden EU-Behörden. Rückverfolgungen der Lebensmittel wiesen auf sieben Endproduzenten in Polen sowie einem in Österreich hin, doch seien keine mikrobiologischen Hinweise für eine Verunreinigung in deren Produktionsstätten gefunden worden.
In Deutschland gab es in diesem Jahr in dem Zusammenhang insgesamt 18 Fälle, wie aus der Einschätzung hervorging. Neun Erkrankte in drei Ländern mussten den Angaben zufolge im Krankenhaus behandelt werden, in Österreich ist eine Person in Folge der Erkrankung gestorben.
© dpa-infocom, dpa:231027-99-719616/3